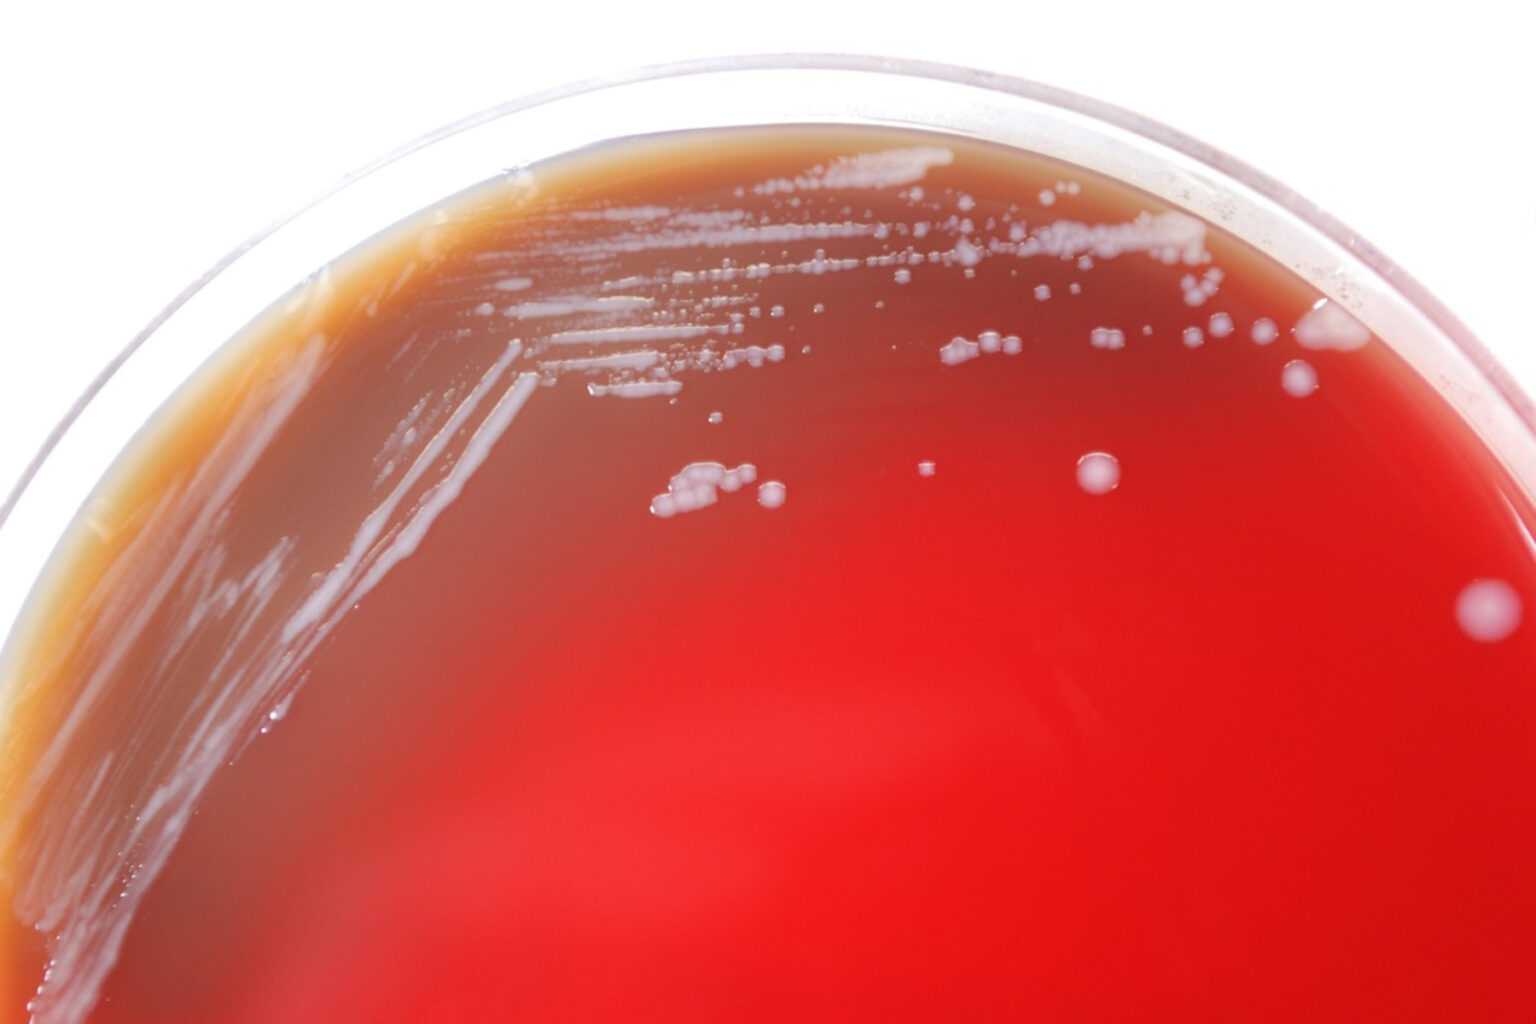

Ένας δυνητικά θανατηφόρος τύπος βακτηρίου που προηγουμένως βρέθηκε μόνο σε περιοχές της Νότιας Ασίας, της Αφρικής ή της Αυστραλίας ανιχνεύτηκε για πρώτη φορά σε δείγματα εδάφους και νερού στις ΗΠΑ, ανακοίνωσε την Τετάρτη το Κέντρο Ελέγχου και Πρόληψης Νοσημάτων. Το βακτήριο, Burkholderia pseudomallei, μπορεί να προκαλέσει μια ασθένεια που ονομάζεται μελιόδωση, η οποία έχει αποδειχθεί θανατηφόρα στις μισές περιπτώσεις παγκοσμίως.

Θανατηφόρο βακτήριο
Περίπου δώδεκα κρούσματα ανακαλύπτονται κάθε χρόνο στις ΗΠΑ, συνήθως μεταξύ ανθρώπων που είχαν ταξιδέψει στο εξωτερικό. Την Τετάρτη, ωστόσο, το CDC ανακοίνωσε ότι το βακτήριο είχε βρεθεί σε δείγματα εδάφους και νερού κατά μήκος της ακτής του Κόλπου του Μισισιπή και εξέδωσε προειδοποίηση υγείας σε γιατρούς σε όλη τη χώρα να είναι σε επιφυλακή για συμπτώματα μελιόδωσης, τα οποία μπορεί να είναι ασαφή. συμπεριλαμβανομένου του βήχα, του πυρετού και του πόνου στο στήθος. Σε πιο σοβαρές περιπτώσεις, η ασθένεια μπορεί να οδηγήσει σε αποπροσανατολισμό, πνευμονική ασθένεια και επιληπτικές κρίσεις.
“Δεν είναι σαφές πόσο καιρό τα βακτήρια βρίσκονται στο περιβάλλον και πού αλλού μπορεί να βρεθούν στις ΗΠΑ”, ανέφερε σε ανακοίνωσή του το CDC. Η Δρ Τζιλ Γουέδερχεντ, επίκουρη καθηγήτρια τροπικής ιατρικής και μολυσματικών ασθενειών στο Baylor College of Medicine στο Χιούστον, δεν εξεπλάγη που το βακτήριο είχε εισέλθει στη χώρα. “Ζούμε σε ένα υποτροπικό κλίμα εδώ στις ΗΠΑ κατά μήκος της ακτής του Κόλπου, όπου είναι ζεστό και υγρό. Αυτό είναι ένα κατάλληλο περιβάλλον για την Burkholderia pseudomallei”, είπε. Το βακτήριο έχει τη δυνατότητα να ευδοκιμήσει οπουδήποτε κατά μήκος της ακτής του Κόλπου, είπε, και θα μπορούσε να γίνει ενδημικό.
Η ανακάλυψη του βακτηρίου στο έδαφος των ΗΠΑ έρχεται αφότου δύο άτομα που δεν είχαν συγγένεια αλλά ζούσαν ο ένας κοντά στον άλλο στο Μισισιπή αρρώστησαν με μελιόδωση — το ένα το 2020 και το άλλο το 2022. Σύμφωνα με την προειδοποίηση υγείας του CDC για τους γιατρούς, και οι δύο ασθενείς νοσηλεύτηκαν με σήψη αφού εμφάνισαν πνευμονία. Και στους δύο χορηγήθηκαν αντιβιοτικά και ανάρρωσαν. Δείγματα που ελήφθησαν από το έδαφος και τις λακκούβες κοντά στα σπίτια των ασθενών περιείχαν το βακτήριο, επιβεβαιώνοντας την παρουσία του στις ΗΠΑ, ανέφερε το CDC.
Το ίδιο βακτήριο βρέθηκε επίσης πέρυσι σε μολυσμένο σπρέι δωματίου αρωματοθεραπείας που αρρώστησε τέσσερις ανθρώπους στη Τζόρτζια, το Κάνσας, τη Μινεσότα και το Τέξας. Τα κρούσματα δεν είχαν σχέση με την τρέχουσα ειδοποίηση, καθώς το σπρέι είχε εισαχθεί από την Ινδία, όπου το B. pseudomallei είναι ενδημικό. Δύο από αυτά τα άτομα, μεταξύ των οποίων ένα 5χρονο αγόρι, πέθαναν. Οι άλλοι δύο ασθενείς είχαν διαρκή προβλήματα σωματικής και ψυχικής υγείας. Η Walmart, η οποία πούλησε το εισαγόμενο προϊόν, ανακάλεσε σχεδόν 4.000 μπουκάλια από το Better Homes & Gardens Lavender & Chamomile Essential Oil Spray Room Aromatherapy with Gemstone. Αν και το B. pseudomallei έχει πλέον βρεθεί στο έδαφος και το νερό των ΗΠΑ, οι ειδικοί στις μολυσματικές ασθένειες λένε ότι είναι απίθανο το βακτήριο να προκαλέσει εκτεταμένη βλάβη.

“Χρειάζεται σημαντική έκθεση”, είτε μέσω ανοιχτής πληγής είτε μέσω κατάποσης, για να προκληθούν ασθένειες στους ανθρώπους, είπε ο Δρ Κρις Γουντς, καθηγητής ιατρικής στο Duke Global Health Institute. Συνήθως, είπε, αυτό συμβαίνει σε μέρη όπου το βακτήριο έχει αναπτυχθεί και συγκεντρωθεί. Ενώ η μελιόδωση αντιμετωπίζεται με ορισμένα ενδοφλέβια αντιβιοτικά, οι γιατροί λένε ότι μπορεί να είναι δύσκολο να γίνει σωστή διάγνωση εγκαίρως για να βοηθηθούν οι ασθενείς. Το CDC είπε ότι οι άνθρωποι που ζουν κατά μήκος της ακτής του Κόλπου μπορεί να θέλουν να λαμβάνουν πρόσθετες προφυλάξεις όταν έρχονται σε επαφή με χώμα ή λασπωμένο νερό, όπως να φορούν αδιάβροχες μπότες και να καλύπτουν ανοιχτές πληγές.